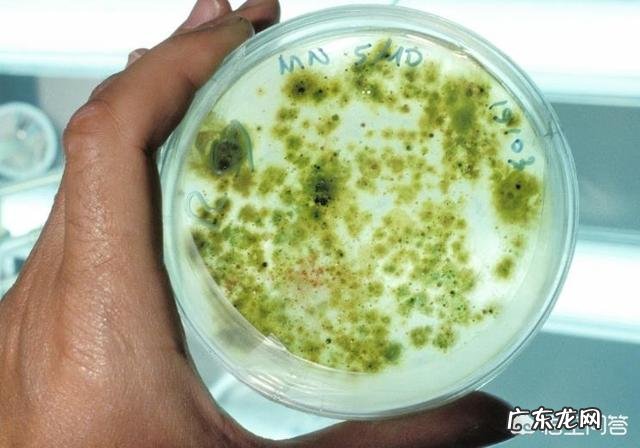

大家好,我是May姐,现在准备为这道题揭晓答案,若你对答案有特别的建议,欢迎在评论区进行留言,赞同可以在右下方点赞,喜欢可以在右上方点关注,我的头条号就是营养师May姐 。螺旋藻是一种药食两用的食物,营养确实很丰富,但也不能依赖或者夸张效果 。

文章插图
它含有丰富的藻多糖,不饱和脂肪酸,藻蓝蛋白,β-胡萝卜素,矿物质镁,铬等,其中镁和铬是可以促进胰岛素分泌、减缓糖吸收、促进物质代谢,抗氧化等,双向调节血糖代谢,维持血糖正常水平;而藻多糖和藻蓝蛋白是增强骨髓细胞的增殖活力,促进胸腺、脾脏等免疫器官的生长并促进血清蛋白的生物合成,因此螺旋藻具有双向调节免疫功能,除其之外,还有抗癌,抗肿瘤等作用 。
文章插图
增加患病风险 。螺旋藻是一种单核细胞,富含大量的核酸,如果把它当成食品,长期摄入,容易造成核酸过多,而核酸并不是机体必需的营养物质,便会增加身体患上痛风或肾结石的风险 。
建议食用螺旋藻之前,要经过专业人士的指导,判断自己的情况是否适合食用,以及自己的食用量最佳是多少 。
有一定的作用 。属于保健食品类的 。想要靠它治病是不现实的 。辅助治疗用的…
希望对你有所帮助 。
【螺旋藻真的有那么多保健功效吗?】有一定的保健作用,但不要过度依赖 。
螺旋藻营养成分的特点是蛋白质含量高, 而脂肪、纤维素含量低, 同时还发现它含有具有防癌、治癌作用的藻类蛋白, 以及其他大量矿质元素和提高机体免疫力的生物活性物质 。
1、螺旋藻内含有很高的植物性蛋白质以及丰富的叶绿素、β-胡萝卜素等,这些营养物质对胃酸中和及胃肠道粘膜修复、再生和正常分泌功能极为有效 。
2、螺旋藻中含有丰富的活性铁、维生素B12和叶绿素,因此螺旋藻能从多方面促进血红蛋白合成和骨髓造血功能,发挥抗贫血的作用 。
3、螺旋藻里的Y—亚麻酸可以降低人体所含的胆固醇,从而可以有效降低高血压和预防心脏病减低胆固醇 。
4、螺旋藻中藻多糖、β- 胡萝卜素、藻蓝蛋白均有此作用,因此螺旋藻在抗肿瘤、防癌方面显示出重要作用 。
- 榧木的特征有哪些?
- 幕墙施工的工序有哪些
- 水钻钻头都有什么尺寸
- 角色扮演游戏有哪些 角色扮演小游戏有哪些
- 你觉得有哪些影视角色一个演员演绎过后就无人能超越了?
- 带孩子出门旅游,有哪些儿童安全行为和措施是要注意的?
- 有哪些适合女生减肥时吃的零食?
- 第一次拔牙应该注意什么?
- 有人说:男人,肾功能好,一般有10个表现,具体都指哪些?又该如何养护肾脏健康?
- 生化危机恐怖游戏下载 生化危机网站
特别声明:本站内容均来自网友提供或互联网,仅供参考,请勿用于商业和其他非法用途。如果侵犯了您的权益请与我们联系,我们将在24小时内删除。
